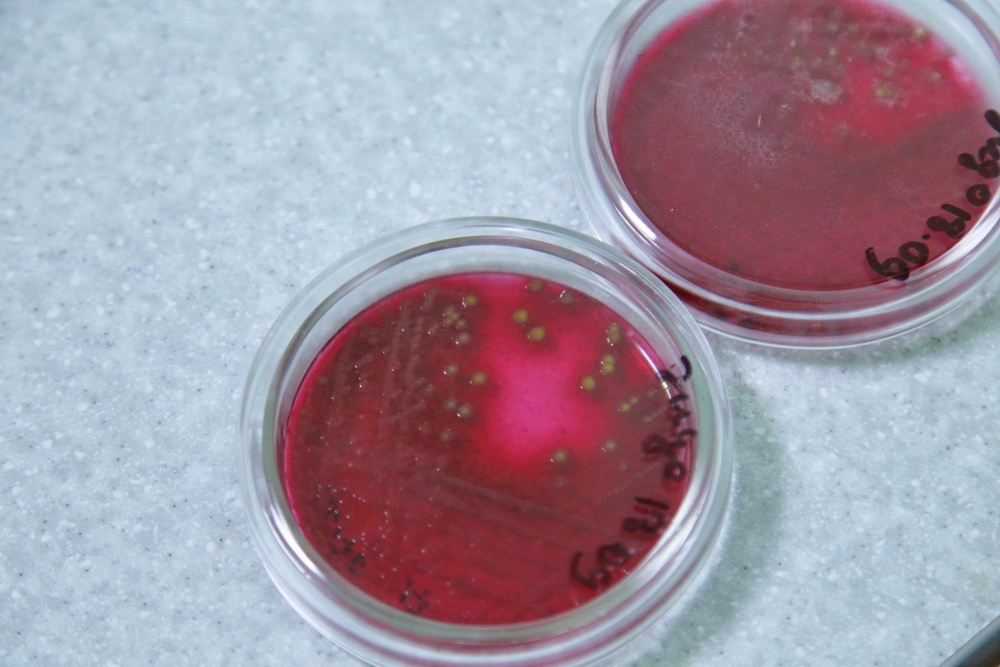

Еда живая и мёртвая: как проверить качество продуктов
Какого цвета сальмонелла, почему нужно нюхать жабры и зачем лаборанты пользуются ароматическими шариками — «Новосибирские новости» посетили испытательную лабораторию и узнали, как провести домашнюю экспертизу продуктов, а что лучше доверить лаборантам.
Наталия Лавриченко
Два кусочка колбаски
Тут полный контроль: контролируют воздух, воду из крана и чистоту рук. Чтобы попасть в стерильную зону, нужно пройтись по специальному матрасику с обеззараживающим средством. Поэтому женщины здесь ходят не в туфельках, а в белых кожаных тапках. Перед тем, как пойти работать в чистую зону, нужно сходить в душ и надеть спецодежду.

Фото: Павел Комаров, nsknews.info
Испытательная лаборатория выглядит достаточно эффектно. В помещении среди бесчисленного количества стеклянных колб и реагентов работают специальные аппараты, которые монотонно гудят и переливают разноцветную жидкость. Как поясняет директор испытательно-лабораторного комплекса при Новосибирском аграрном университете Лариса Орсич, проверка товаров в лаборатории — дело крайне трудоёмкое.

Фото: Павел Комаров, nsknews.info
«Обычный человек приносит мясо, но на что именно проверить это мясо, он не знает. Мы как профессионалы должны определить, какие показатели возможно выявить у продукции и какие методики для этого нужны».

Фото: Павел Комаров, nsknews.info
Лабораторные испытания продуктов происходят, кстати, далеко не так, как многие себе представляют — кусок колбасы не рассматривают под микроскопом и не капают на продукт различными химикатами. В начале процесса специалисты обязательно проводят пробоподготовку. Другими словами, объект испытаний сильно измельчают (гомогенизируют), а далее помещают в специальную среду.
Развели тут микроорганизмы
Где-то за стенкой гремят кастрюлями: лаборанты готовят питательные среды для выращивания микроорганизмов. Такой тест даёт понять, есть ли в продукте плесень, бактерии или грибки.

Фото: Павел Комаров, nsknews.info
Вообще, микроорганизмы всегда присутствуют в нашей среде, многие из них полезны и даже необходимы для нашего здоровья. Однако некоторые являются патогенными и могут вызвать болезнь.

Фото: Павел Комаров, nsknews.info
Процесс напоминает приготовление супа — на вид какого-то овощного. Из кастрюли питательную среду разливают по чашкам Петри, помещают туда исследуемый материал и ждут до трёх суток.

Фото: Павел Комаров, nsknews.info
Чашка с содержимым может остаться чистой, значит, с продуктом всё в порядке. А может вырасти целая колония. Быстрее всего растёт плесень, всего за неделю.

Фото: Павел Комаров, nsknews.info
«Вот тут у нас подозрение на кишечную палочку. Их различают по цвету — они всегда малинового цвета с металлическим блеском. У сальмонеллы — чёрный узор, у листерии вырастают оливковые колонии с определённым ободком», — демонстрирует чашки Петри лаборант.
Фото: Павел Комаров, nsknews.info
В лаборатории усиливается неприятный запах. Это начинают «благоухать» микроорганизмы. Похоже на запах гнилых зубов. Запах въедливый, поэтому лаборантам приходится надевать респираторы и раскладывать вокруг себя дезодорирующие шарики.

Фото: Павел Комаров, nsknews.info
Отработавшие питательные среды потом загрузят в автоклав и заново переварят, а затем утилизируют.
Гриб в пробирке
В химическую лабораторию завезли муку — её будут испытывать на содержание клейковины. Муку моют в воде (как бы это странно ни звучало) до состояния шарика — это и будет клейковина. Чтобы выделить из содержимого белок, нужно применить борную или серную кислоту.

Фото: Павел Комаров, nsknews.info
Кругом всё булькает и кипит. Столы у лаборантов выглядят устрашающе, на столешницах и стенах повсюду пятна и брызги от серной кислоты, как будто кто-то разрисовал их разноцветными красками.

Фото: Павел Комаров, nsknews.info
Аппаратура приходит на помощь человеку, когда необходимо, например, чтобы определить наличие этанола в спиртных напитках или дозу селена в креветках или семечках.

Фото: Павел Комаров, nsknews.info
Агрегат под названием хромотограф выводит на листе кардиограмму. Знающий человек по ней определит доскональный состав алкоголя.

Фото: Павел Комаров, nsknews.info
Узнать долю жира в шоколаде можно будет только после того, как его размочат, пропустят через центрифугу, а потом высушат.

Фото: Павел Комаров, nsknews.info
Или вот грибы. Чтобы получить из них экстракт, их помещают в специальную болтушку. Пока человек занимается своими делами, грибы болтаются туда-сюда в колбе, потом жидкость переливают и из неё добывают нужный для анализа экстракт.

Фото: Павел Комаров, nsknews.info
«В целом продукты питания не вызывают особых нареканий, хотя бывают, конечно, исключения. Производители идут на ухищрения, добавляют добавки, которые влияют на качество продукта», — делятся сотрудницы лаборатории.
Лаборатория & домашняя экспертиза
Мы решили выяснить, какими доступными способами покупатель сам может определить свежесть мяса или рыбы, а какие проверки доступны только в лаборатории.
Овощи и фрукты

Фото
Проверка в лаборатории
Овощи и фрукты проверяют на органолептику — внешний вид, отсутствие гнили, плесени, повреждений грызунами. Но для этого не нужно быть специалистом: все деформированные и испорченные овощи покупатель может и сам выявить на прилавке. А вот проверка на нитраты — это прерогатива только лаборантов.
Домашняя экспертиза
Можно купить свой собственный нитрат-тест или нитратомер. Он очень прост в использовании — воткнул в продукт, и тестер показывает на экране содержание нитратов.
Перед тем как есть сырые овощи и фрукты, замочите их в воде на 30 минут. Особенно это касается редиса и огурцов. Половина нитратов останется в воде.
Мясо

Фото
Проверка в лаборатории
Если свежесть вы хоть как-то можете определить, то наличие заболеваний и мелких глистов без лабораторных исследований — никогда. В лаборатории по внешнему виду внутренних органов, мышечной ткани, крови специалисты могут определить, чем болело животное. Некоторые опасные для человека заболевания, например, трихинеллёз (мелкие глисты), выявляют под микроскопом.
Домашняя экспертиза
Покупая на рынке мясо, требуйте заключение лаборатории ветеринарной экспертизы. На нём должна стоять только сегодняшняя дата. У хорошего мяса приятный запах, без примеси кислинки и хлорки. Если нажать на филе пальцем, то свежий продукт быстро восстановит форму.
Рыба

Фото
Проверка в лаборатории
На рынке могут продавать морскую замороженную рыбу и пресноводную. Последняя должна находиться либо живой в ёмкости с водой, либо разделанной и охлаждённой льдом. В лаборатории пресноводную рыбу проверяют на гельминты, а замороженную — на условия хранения и сроки реализации.
Домашняя экспертиза
Жабры о рыбе могут сказать всё. Они должны хорошо прилегать к тушке, иметь красный, но не бурый цвет. Всегда нюхайте жабры. Именно с них начинает портиться рыба. При разрезе рыбы внутренние органы должны оставаться целыми, а кости не должны отходить от тушки.
Молоко

Фото
Проверка в лаборатории
В лаборатории молоко проверяют на кислотность, жирность, мастит, фальсификат. Из каждой банки берут в среднем на пробу 250 мл. Если молоко признают опасным для человека, всю партию изымают до полного излечения коровы.
Домашняя экспертиза
Домашние молоко и сметану на рынке можно продавать только в стеклянной посуде (так как пластик нельзя мыть кипячёной водой). Творог — на чистых подносах и прикрытым марлей. Также эти продукты не должны лежать возле овощей или мяса.
Дома можно определить, разбавляли ли молоко крахмалом или водой. Для этого капните в стакан молока немного йода. Если цвет не изменился или стал желтоватым, всё в порядке. Если же молоко получило голубоватый оттенок, в нём есть крахмал.
Консистенцию продукта тоже можно определить на глаз. Перелейте молоко в другую ёмкость. Если на банке остался осадок, оно неразбавленное.
Яйца

Фото
Проверка в лаборатории
На рынке разрешено продавать только куриные и перепелиные яйца. Яйца гусей, уток, индеек опасны и могут содержать сальмонеллёз.
Лаборант проверяет яйца по внешним показателям — целостность, чистота, а также наличие внутри кровяных или черных пятен: их быть не должно. Специальный прибор помогает заметить их даже в неразбитом яйце.
Домашняя экспертиза
Есть понятие диетического яйца, которому семь дней. Оно самое свежее и полезное. Именно такое яйцо можно пить сырым.
Если хранить яйца правильно, то их можно есть без опаски и через три месяца, а в холодильнике (при +4 градусах) этот продукт может спокойно лежать 120 дней.
Налейте в стакан кипячёную охлаждённую воду, добавьте чайную ложку соли и поместите в неё сырое яйцо. Диетическое свежее яйцо опустится на дно и будет лежать ровно. Если яйцо поднялось одним боком на несколько градусов, ему около 14 дней. Если встало вертикально, уже истекло полсрока хранения. А если яйцо всплыло — оно тухлое.
Материал впервые был опубликован на сайте «Новосибирские новости» 23 октября 2017 года.





